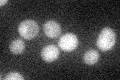
YLR218C
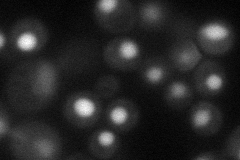
YLR218C
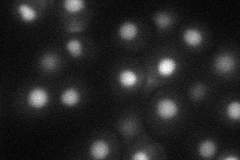
YLR218C
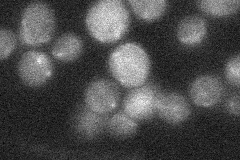
YLR218C
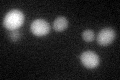
YLR218C
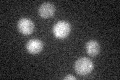
YLR218C

View description
Protein that localizes to the mitochondrial intermembrane space via the Mia40p-Erv1p system; mutants exhibit glycogen storage defects and growth defects on a non-fermentable carbon source; contains twin cysteine-x9-cysteine motifs
Localization:
Intensity:
Fold change:
Significance:
-
C’ GFP library in SD
cytosol27.41 -
N' NOP1pr-GFP in SD
nucleus38.6546 -
N' TEF2pr-mCherry in SD
nucleus23.9865 -
N' NATIVEpr-GFP in SD
below threshold18.1821 -
N' TEF2pr-VC and Cyto-VN in SD

#N/A0 -
C’ GFP library in SD+DTT
cytosol30.791.12No -
C’ GFP library in SD+H2O2

cytosol23.80.86No -
C’ GFP library in Starvation Media
cytosol23.820.86No -
C’ GFP library on the background of Pup2-DaMP

cytosol -
C’ GFP library on the background of CCT mutant

cytosol22.01350.802872No
